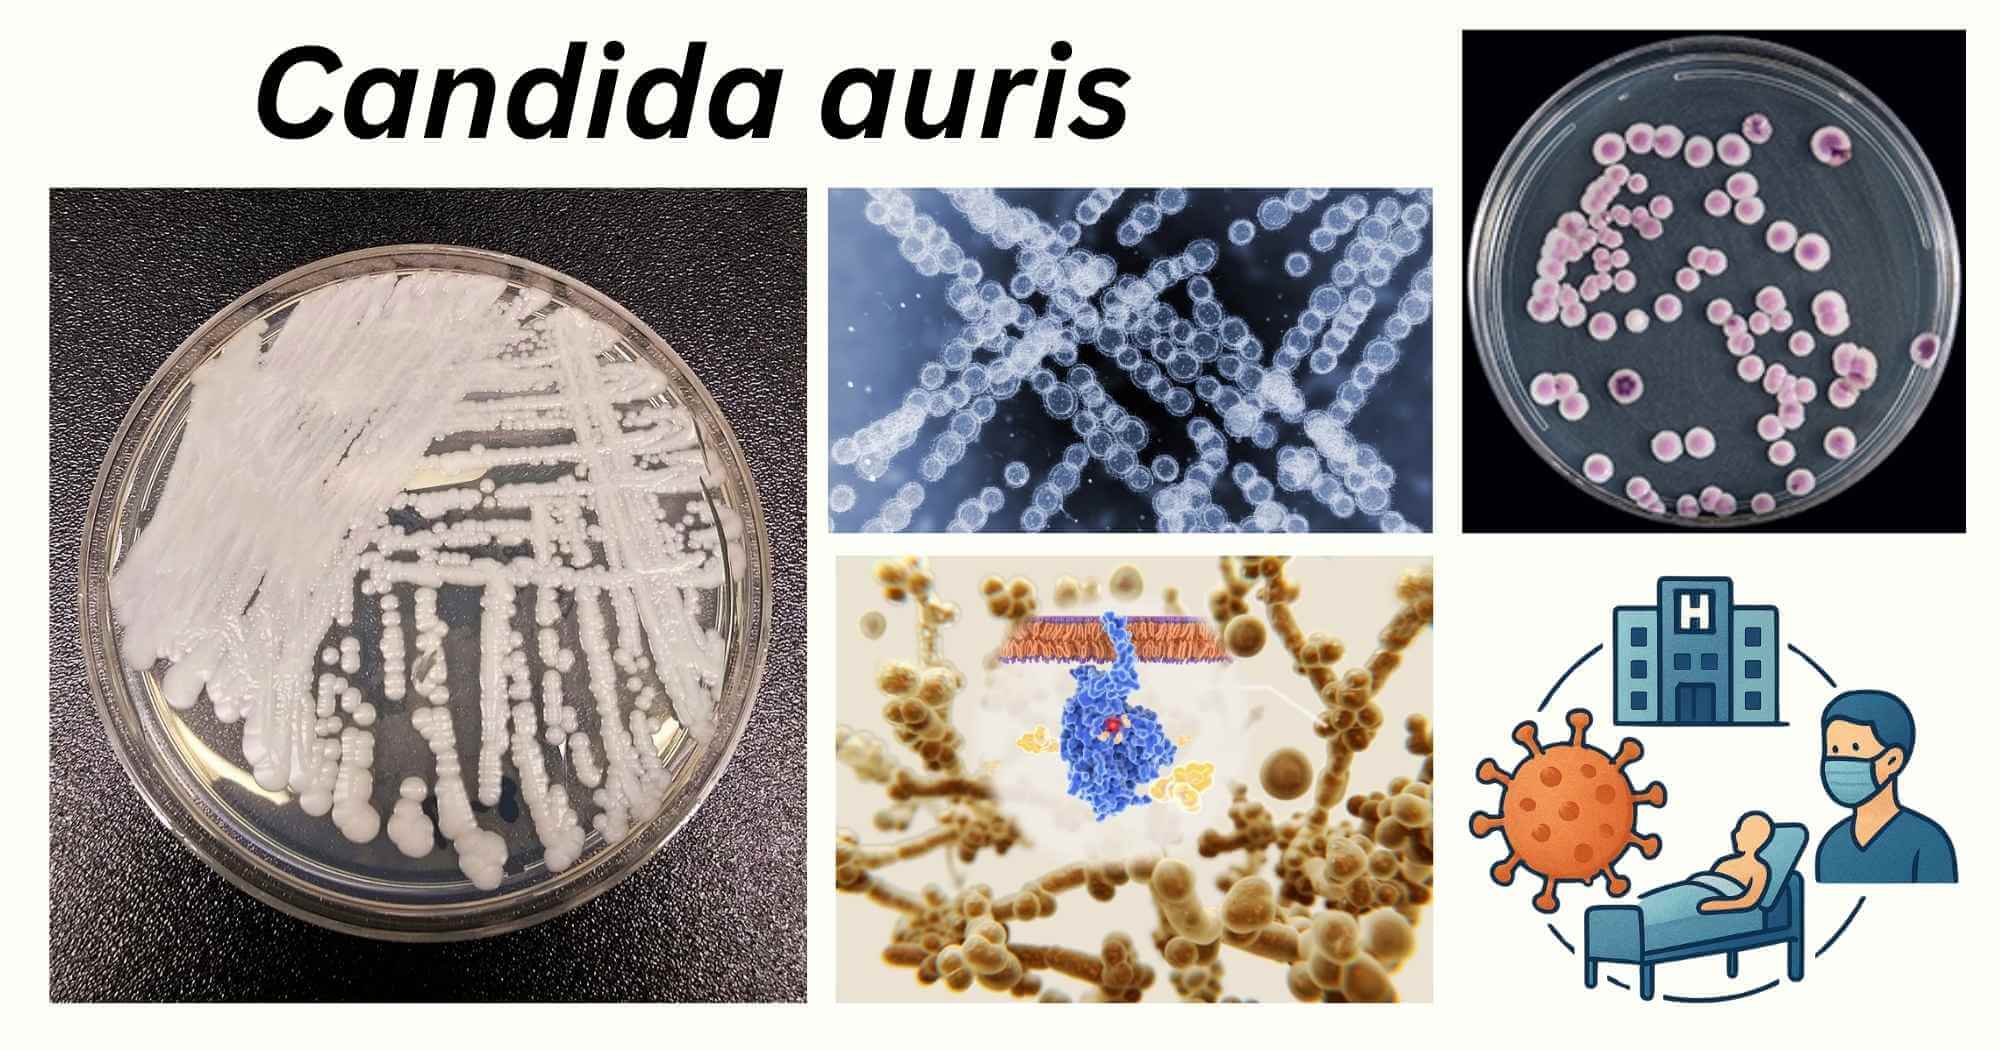
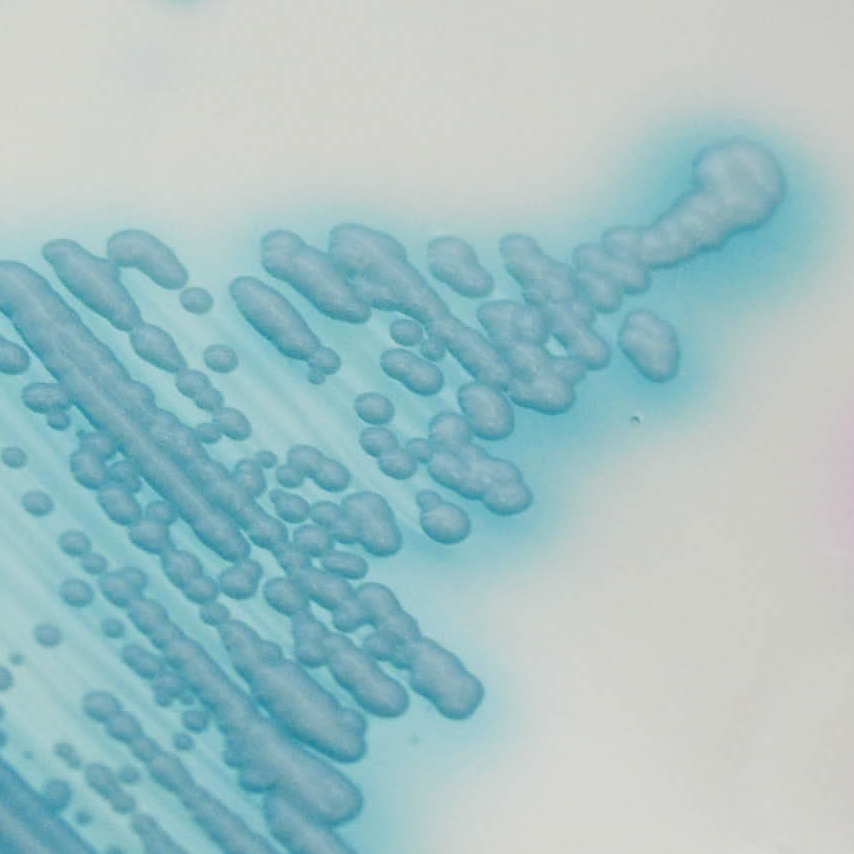
image 107 Light blue colonies of C. auris

Candida auris is an opportunistic, invasive fungal pathogen that mainly causes nosocomial infection, ranging from superficial to systemic mycoses.
C. auris was first isolated from the ear canal (hence the name “auris”) of a 70-year-old Japanese patient in 2009.
- C. auris is deemed a rapidly emerging (across 40 countries), multidrug-resistant yeast and a big threat to the public health system, due to its high mortality rate.
- In 2022, the WHO classified C. auris as a critical priority fungal pathogen due to all these aforementioned crises it causes in health care settings.
Introduction to Candida auris
- C. auris belongs to the Candida/Clavispora clade of the Metschnikowiaceae family and is closely related to other haploid fungal species like C. lusitaniae and C. haemulonii.
- It is often misdiagnosed as C. haemulonii when the conventional yeast identification method is implemented.
- It is a member of the CTG clade (which translates the CTG codon into serine instead of leucine).
- C. auris has been classified into 6 clades based on geographic and genetic variations:
- South Asian Clade (I): First discovered in India and Pakistan.
- East Asian Clade (II): First discovered in Japan
- South African Clade (III): First discovered in South America
- South American Clade (IV): First discovered in Venezuela
- Clade V: Recently discovered in Iran
- Clade VI: Recently discovered in Singapore
- Thousands of single-nucleotide polymorphisms (SNPs) are observed between different clades, which makes their emergence, evolution, and adaptation distinct from one another.
- Clades I, III & IV have been responsible for nosocomial outbreaks and invasive forms of infections, whereas clades II & V mainly cause otomycosis.
Morphology of Candida auris
- The shape of yeast cells ranges from ovoid to ellipsoidal to elongate.
- It measures 2.5-5μm.
- Pseudohyphal form is present during the formation of biofilm.
Reservoir of Candida auris
The origin of C. auris is still not clear. Its sudden emergence across different continents is hypothesized to be due to the temperature rise caused by global warming.C. auris has high halo tolerance (10% NaCl) and thrives in temperatures ranging from 37° to 40°C. This attribute has been crucial for C. auris to survive on skin and consequently cross the mammalian barrier and cause infection.
Natural Environmental Reservoir
- The aquatic biome has been a very prominent reservoir for C. auris. It has been isolated from the coastal wetland, seawater, and beach sand.
- Its presence in this biome has led to its contamination of amphibian life, like that identified on the skin of the Smooth newt and northern crested newt.
- It has been an etiological agent to cause otitis in dogs.
- C. auris has also been found in air-borne dust in Kuwait, which may be due to flakes of skin shed by the carrier.
Non-Hospital Reservoir
- C. auris is known to colonize the human skin, especially the armpits and groin. It is found in human excrement and eventually is detected in wastewater plants.
- A study also found its presence in swimming pools in the Netherlands.
Hospital Reservoir
- The skin colonized with C. auris acts as a carriage and contaminates the frequently touched surface and re-useable medical devices like axillary temperature probes.
- In the hospital, the yeast was detected near the patient’s bed, medical equipment like an ECG clip, an oxygen mask, and portable devices like a wheelchair and an intravenous pole.
Lifecycle of the biofilm of Candida auris
C. auris forms a biofilm that consists mainly of yeast cells and pseudohyphal cells enclosed by an extracellular matrix made of mannan and glucan. 4 stages are involved in this process:
- Adherence stage: The planktonic yeast cells attach to a surface, which can be classified as a biotic (skin) and an abiotic (catheters, keyboard).
- Initiation stage: The adhered cells multiply and form both yeast and pseudohyphal cells.
- Maturation stage: Extracellular matrix is encased over the proliferated cells.
- Dispersal stage: Some yeast cells detach from the adhered surface and attach to other new surfaces, hence continuing the cycle of biofilm formation and eventually transmitting the infection.

Source: doi: 10.3389/fcimb.2021.713092
Transmission of Candida auris Infections
- The transmission occurs exogenously. Unlike C. albicans, C. auris is not a part of the human microbiota. The yeast colonizes the skin (mainly the armpit and groin) of the carrier (hospital worker in a healthcare setting).
- When the carrier does not properly follow the sanitization procedure, they tend to spread C. auris via human-human contact, in medical equipment, patient’s hospital beds, curtains and hence start the cascade of nosocomial infection.
- Outside the healthcare setting, zoonotic transmission is also possible.
- The yeast can survive for a very long duration on fomites and skin.
Clinical Manifestation of Candida auris
- The population vulnerable to C. auris infection includes geriatric persons and those with underlying diseases like diabetes mellitus, hypertension, renal disease, etc., or those undergoing immunosuppressive therapy.
- It causes superficial to invasive infection. The most common being bloodstream infections, which can disseminate into other organs.
- The rising antifungal resistance has increased the mortality rates (30-70%).
Identification
Culture
- On CHROMagarTM Candida plus medium, C. auris gives light blue color colonies with a blue halo at a temperature of 42°C and an incubation period of 36h. The media is deemed to have a sensitivity and specificity of 100%.
Source: https://www.chromagar.com/en/product/chromagar-candida-plus/
Molecular methods
- Matrix-Assisted Laser Desorption Ionization-Time of Flight mass spectrometry (MALDI-TOF MS) for species identification.
- Sequencing the specific location, like the D1/D2 domain of 28s rDNA or the Internal Transcribed Spacers ITS1 & ITS2 region of rDNA (ribosomal DNA).
- Whole Genome Sequencing (WGS) and typing by Multilocus Sequence Typing (MLST) help reveal the genetically distinct strains.
Virulence factor of Candida auris
Biofilm formation
- The aggregate of cells enclosed in an extracellular matrix has a high level of antifungal resistance compared to planktonic (free-floating) cells.
- The yeast cells attach to human tissue or medical devices and form biofilm, survive for a longer duration, and eventually become the mode of transmission in nosocomial infection.
- Glycosylphosphatidylinositol (GPI)-anchored cell wall genes like IFF4, CSA1, PGA26 & PGA52 are upregulated in all stages of biofilm formation and play a pivotal role because it encodes proteins necessary for adhesion.
Morphological plasticity
- 3-way phenotypic switching is observed in C. auris: Typical Yeast form, Filament-Competent yeast cells, and Filament form.
- Typical yeast cells are filament-incompetent.
- FC yeast is morphologically similar to typical yeast cells but functionally similar to filamentous form.
- Transition from the typical yeast form to Filamentous-Competent yeast cells is a heritable phenotype switching. In contrast, the transition between Filamentous-Competent yeast into Filament form is a non-heritable phenotype switch induced by low temperature (25°C).
- Fatty-acid (β-oxidation) metabolism genes are upregulated in the filamentous phenotype. Fatty acids provide a slower but long-term energy supply in the nutrient-depleted environment of the skin, hence ensuring long-term survival.
- This phenotype switching into filamentous form helps the cells to adapt properly to the skin.
Secreted Aspartyl Protease (SAP)
- SAP is one of the crucial virulence factors in pathogenic fungi as it breaks down the host structural protein by cleaving the peptide bonds.
- Gene encoding SAP is differentially expressed in typical yeast form, where expression is upregulated, and in filamentous form, under certain conditions, only upregulates the expression (at 37°C).
- Low expression level of SAP genes corresponds to less virulence factor and hence better colonization of the skin without inducing pro-inflammatory response.
Resistance mechanism of Candida auris
Clade II is susceptible to fluconazole, while clade I C. auris is deemed to be highly resistant to fluconazole (97%) and amphotericin (40-50%). Clade III & clade IV show high resistance to echinocandin (7%).
Efflux pump gene upregulation during maturation of biofilm
- Genes that code for ATP-Binding Cassette transport (CDR1, SNQ2) & Major Facilitator Superfamily transporter (MDR1) are highly upregulated during intermediate and mature stages of biofilm formation.
- These genes are inherently resistant to azoles because of it is constitutively expressed and not induced by a stimulus (e.g., fluconazole).
The ERG11 gene mutation leads to fluconazole resistance
- The major component of the fungal cell membrane is ergosterol. Antifungals like azoles and polyenes target the biosynthesis of ergosterol by targeting lanosterol demethylase, which is encoded by ERG11.
- A mutation in ERG11 causes a change in the amino acid sequence like that seen in Y132F, K143R & F126L. This phenomenon changes the drug target site of fluconazole by changing the shape of the target (target-site-mediated resistance), which leads to resistance.
- K143R is responsible for cross-azole resistance.
Echinocandin resistance
- FKS genes (FKS1, FKS2 & FKS3) encode the enzyme β-(1-3)-D-glucan synthase that synthesizes the fungal cell wall. Echinocandins target this specific enzyme to exhibit their antifungal effect.
- Point mutation in FKS1 changes amino acid sequence S639F, S639Y, F635P & S635P and leads to target-site-mediated resistance.
Therapeutic option of Candida auris
- Echinocandin is regarded as the first-line antifungal treatment when the strain becomes resistant to fluconazole. If the treatment becomes ineffective, liposomal Amphotericin-B is regarded as an alternative.
- Emerging antifungals like rezafungin have been favorable in treating invasive candidiasis.
Prevention of Candida auris
- Chlor-Clean of concentration of 1000ppm and Haz-Tab of concentration of 10,000ppm are very effective in eliminating C. auris from clinical isolates within 3minutes.
- Integration of peracetic acid and NaOCl has been potent in killing C. auris from various surfaces like glass, steel, porcelain, and plastic.
- Screening of patients who were in contact with those with C. auris infection should be strictly maintained.
Conclusion
Multidrug-resistant yeast has already been posing a dire situation in healthcare settings, making treatment difficult due to simultaneous or sequential integration of multiple drug resistance mechanisms and severely limiting therapeutic options. Changing environmental conditions have catalyzed this situation exponentially by providing added benefit for the emergence of new pathogenic microbes.
Reference
- Bapat, P.S. & Nobile, C.J. (2021). Photodynamic Therapy is Effective Against Candida auris Biofilms. Front. Cell Infect. Microbiol., 11, 713092. doi: 10.3389/fcimb.2021.713092
- Du, H., Bing, J., Hu, T., Ennis, C.L., Nobile, C.J. & Huang, G. (2020). Candida auris: Epidemiology, biology, antifungal resistance and virulence. PLoS Pathog, 16(10),
- De Gaetano, S., Midiri, A., Mancuso, G., Avaola, M.G. & Biondo, C. (2024). Candida auris Outbreaks: Current Status and Future Perspectives. Microorganisms, 12, 927. doi: 10.3390/microorganisms 12050927
- Kean, R., Delaney, C., Sherry, L., Borman, A., Johnson, E.M., Richardson, M.D., Rautemaa-Richardson, R., Williams, C. & Ramage, G. (2018). Transcriptome Assembly and Profiling of Candida auris Reveals Novel Insights into Biofilm-Mediated Resistance. mSphere, 3, 10. doi: 10.1128/msphere.00334-18
- Silva, I., Miranda, I.M. & Costa-de-Oliveira, S. (2024). Potential Environmental Reservoirs of Candida auris: A Systematic Review. J. Fungi, 10, 336. doi: 10.3390/jof10050336
- Yue, H., Bing, J., Zheng, Q., Zhang, Y., Hu, T., Du, H., Wang, H. & Huang, G. (2018). Filamentation in Candida auris, an emrging fungal pathogen of humans: passage through the mammalian body induces a heritable phenotypic switch. Emerging Microbes & Infections, 7, 188. doi: 10.1038/s41426-018-0187-x